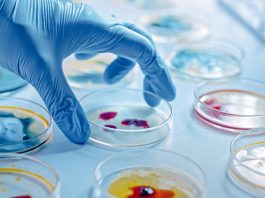

UK study will involve repeat COVID-19 testing in UK care homes
A new surveillance study to be carried out in the UK will offer 100 care homes repeat COVID-19 testing.
The study aims to offer a...
Study shows 99.9% of coronaviruses killed by far-UVC light
A new study has shown that 99.9% of coronaviruses can be killed when exposed to far-UVC light.
The study, carried out by researchers at Columbia...
New recommendations for releasing COVID-19 patients from isolation
The World Health Organization has released new recommendations for releasing COVID-19 patients from isolation.
Care must be taken when releasing COVID-19 patients from isolation in...
Mobile intercom solution for self-isolating and reduced mobility elderly
An innovative new mobile intercom could offer a solution for elderly people who are self-isolating, and who live with mobility or sensory issues.
Opening the...
Study reveals face masks are vital in controlling COVID-19 spread
A new study has revealed that the use of face masks is vital for controlling COVID-19 spread.
Whether face masks are useful in controlling the...
UK scientists suggest two-step strategy to lift COVID-19 lockdowns
Scientists have predicted the best strategy for lifting the COVID-19 lockdowns across Europe.
Currently, many countries across the continent are lifting and relaxing COVID-19 lockdowns,...
Infection control guidance for dental clinics, GP practices, and pharmacies
The European Centre for Disease Prevention and Control (ECDC) has published infection control guidance for healthcare providers in Europe.
If healthcare services across Europe are...
Care providers could face £6bn extra in COVID-19 infection control costs
New research has highlighted that COVID-19 infection control costs could see care providers in the UK facing a bill of an extra £6bn.
Providing Personal...
UK COVID-19 taskforce and testing will help care sector control infection
The UK Government has confirmed that a new social care sector taskforce has been set up, and testing is to be rolled out across...
Virtual infection control and mental health education
The virtual Mental Health First Aid and Infection Control education courses have been created to help support people working or volunteering in the care...
Developing new approaches to COVID-19 infection control and patient care
Physicians have put forward an approach to create dedicated COVID-19 patient units, infection control protocols, and care teams to help control the spread of...
Controlling spread of COVID-19 infection indoors needs to be a priority
Experts have said that controlling the spread of the COVID-19 infection indoors should be ‘the next front of the battle against the virus’.
Experts from...
Evidence on optimal use of PPE and physical distancing to stop COVID-19
A new, comprehensive review has provided evidence for the first time on the optimal use of Personal Protective Equipment (PPE) and physical distancing to...
‘Deep concern’ over care home Infection Control fund
The director of ADASS has warned of the ‘deep concern’ raised by confusion over the £600m Infection Control fund recently announced by the UK...
Breakthrough ultraviolet light development could help kill COVID-19 virus
Ultraviolet (UV) light is a commonly used method for killing bacteria, but could it help with disinfecting areas contaminated with COVID-19? A breakthrough discovery...
Urgent infection control reform needed in hospitals worldwide
Infection control reform in hospitals and care homes across the globe is needed urgently, say experts.
The COVID-19 pandemic has presented new challenges for healthcare...
Government issues COVID-19 workplace infection control guidance
Following the launch of the Government’s test and trace service, it has issued COVID-19 infection control guidance for the workplace.
From today people in England...
Local authorities to work with NHS to contain COVID-19 infections
Local UK authorities will work alongside the NHS and stakeholders to develop tailored outbreak control plans in a bid to contain COVID-19 infections.
Local authorities...
Infection control market expected to reach €26.63bn by 2025
Analysis has shown that the infection control market is expected of reach in excess of USD €26.63bn by 2025.
The infection control market expected to...
Government risks second COVID-19 spike if schools re-open says SAGE
The independent SAGE committee has stated that schools should not re-open on June 1 because there is ‘no clear evidence’ that it is safe...